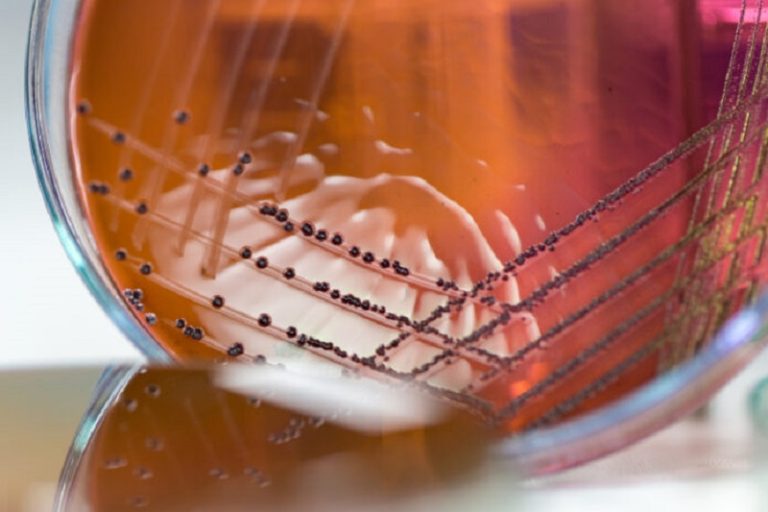
Bacterias

Un nuevo informe identifica lagunas crÃticas en el desarrollo de tratamientos contra infecciones multirresistentes, meningitis bacteriana y patógenos en pacientes vulnerables, y pide acelerar la innovación con acceso equitativo.
El documento advierte de un preocupante desfase entre la rápida evolución de las bacterias y el lento desarrollo de nuevos tratamientos, y establece prioridades urgentes para orientar la investigación y desarrollo (I+D) en este campo.
Asimismo, el informe introduce tres nuevos perfiles de producto objetivo (TPP, por sus siglas en inglés) centrados en áreas crÃticas: infecciones graves por bacterias Gram negativas multirresistentes, infecciones por Gram positivas resistentes en pacientes inmunodeprimidos y meningitis bacteriana, tanto comunitaria como asociada a la atención sanitaria.
Un pipeline insuficiente frente a una amenaza creciente
La OMS subraya que, aunque actualmente hay unos 90 antibióticos en desarrollo, solo 15 pueden considerarse realmente innovadores, lo que evidencia una preocupante falta de diversidad en el pipeline. Además, muy pocos de estos candidatos están dirigidos a los patógenos prioritarios definidos por el organismo, especialmente aquellos con mecanismos de resistencia más complejos.
Este déficit es especialmente alarmante en el contexto de la resistencia antimicrobiana (RAM), que sigue aumentando a nivel global impulsada por el uso generalizado de antibióticos. Según el informe, los tratamientos actuales —incluso combinados con los aprobados en los últimos años— son insuficientes para frenar la expansión de infecciones resistentes.
Infecciones por Gram negativos
Uno de los focos principales del informe son las infecciones graves causadas por bacterias Gram negativas multirresistentes, como Escherichia coli, Klebsiella pneumoniae, Acinetobacter baumannii o Pseudomonas aeruginosa. Estas bacterias están asociadas a una elevada mortalidad, especialmente en pacientes crÃticos.
En 2021, las infecciones por bacterias Gram negativas resistentes a carbapenémicos causaron aproximadamente 216 000 muertes atribuiblesen todo el mundo, según recoge el documento. Además del impacto en mortalidad, estas infecciones generan una elevada carga asistencial, con estancias hospitalarias prolongadas y mayor necesidad de cuidados intensivos.
La OMS advierte también de que las opciones terapéuticas actuales son limitadas. Aunque existen combinaciones de antibióticos con inhibidores de betalactamasas, su eficacia es incompleta frente a ciertos mecanismos de resistencia, y ya se están detectando casos de resistencia incluso a los tratamientos más recientes.
Pocas opciones frente a Gram positivos resistentes
El segundo perfil de producto se centra en infecciones graves por bacterias Gram positivas resistentes, especialmente en pacientes inmunodeprimidos o crÃticos. En este grupo destacan patógenos como los enterococos resistentes a vancomicina (VRE) o Staphylococcus aureus resistente a meticilina (MRSA).
Estas infecciones presentan tasas de mortalidad elevadas, que pueden alcanzar entre el 25% y el 50% en el caso de bacteriemias por enterococos resistentes en pacientes inmunocomprometidos.
La OMS señala que los antibióticos disponibles presentan importantes limitaciones, como toxicidad, interacciones farmacológicas o pérdida de eficacia. Además, el pipeline es extremadamente reducido: solo dos candidatos en fases tempranas muestran actividad frente a estos patógenos, lo que podrÃa retrasar su disponibilidad clÃnica entre seis y diez años.
Meningitis bacteriana: una amenaza persistente
El tercer eje del informe aborda lameningitis bacteriana, una enfermedad que sigue teniendo una elevada mortalidad y secuelas a largo plazo. Aproximadamente uno de cada seis casos es mortal, y uno de cada cinco pacientes sufre discapacidades permanentes, como pérdida auditiva o deterioro cognitivo.
El problema se agrava por el aumento de resistencias a los antibióticos de primera lÃnea, especialmente en Streptococcus pneumoniae, asà como por la dificultad de muchos fármacos para atravesar la barrera hematoencefálica.
En el caso de la meningitis asociada a la atención sanitaria, los patógenos suelen ser bacterias multirresistentes, lo que complica aún más el tratamiento y aumenta la mortalidad.
Acceso, equidad y uso responsable
Más allá de la innovación, la OMS insiste en que el desarrollo de nuevos antibióticos debe ir acompañado de estrategias para garantizar el acceso equitativo, especialmente en paÃses de ingresos bajos y medios. Muchos de estos fármacos serán antibióticos de «último recurso», lo que puede limitar su disponibilidad por su elevado coste y baja demanda.
El informe también destaca la importancia del uso adecuado de estos medicamentos para evitar la aparición de nuevas resistencias. En este sentido, subraya la necesidad de reforzar los programas de optimización del uso de antibióticos, mejorar el acceso a diagnósticos rápidos y fortalecer la vigilancia global.
Asimismo, se apunta a la necesidad de considerar factores como el impacto en el microbioma, la disponibilidad de formulaciones orales o la inclusión de poblaciones habitualmente infrarepresentadas —como niños, embarazadas o pacientes crÃticos— en los ensayos clÃnicos.
Con estos perfiles de producto, la OMS pretende orientar a investigadores, industria, reguladores y financiadores hacia objetivos concretos que permitan acelerar el desarrollo de antibióticos realmente útiles frente a las amenazas actuales. El mensaje es claro: sin una acción coordinada que combine innovación, financiación, acceso y uso responsable, el mundo se enfrenta a un escenario en el que infecciones comunes podrÃan volver a ser potencialmente mortales.



